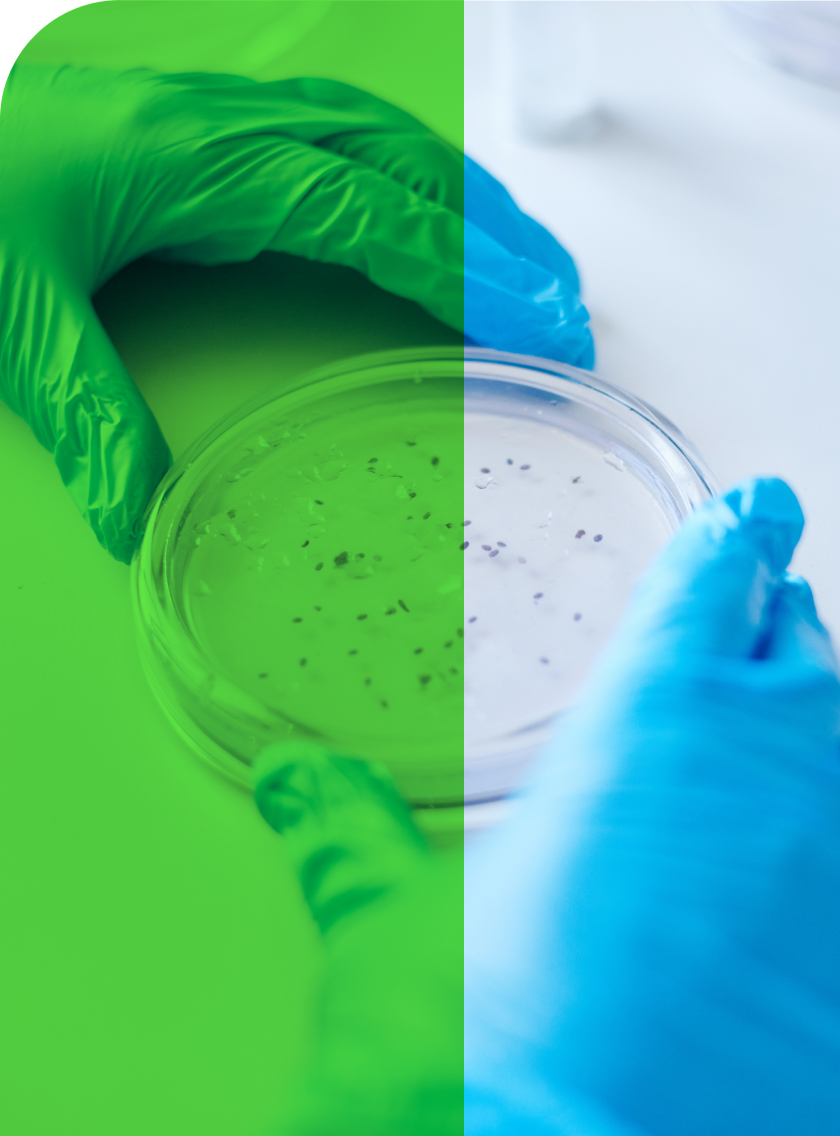

CLSI is uniquely qualified to serve as the go-to source for AST methods and interpretive criteria. Through the implementation of a well-defined, robust standards development program and participation of renowned experts, and by upholding demonstrable practices and principles, CLSI provides world class guidance in antimicrobial susceptibility testing that can be used with confidence to identify and update susceptibility test interpretive criteria.
CLSI AST standards are developed through the work of several commitees and working groups, staffed by subject matter experts from around the world. These teams convene twice annually during our Global Committees Week sessions.